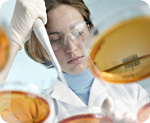

Edible news, articles and information:
 | 4/11/2015 - Following a tragic incident in which a young man killed himself after consuming five times the safe level of edible marijuana, media outlets raised the question of whether recent legalization measures should be rolled back. Unfortunately, such a slant reflects neither the facts of the case nor the real...
|
 | 3/17/2015 5:33:28 PM - Article removed
|
 | 6/20/2014 - Forget the plastic and chemicals: The best food preservatives may actually be all-natural essential oils. New research published in the Journal of Agricultural and Food Chemistry found that an edible film coated in the essential oils of clove and oregano kept bread fresher for longer than conventional...
|
 | 6/8/2014 - Most of us have seen one of those "survival shows" on television, in which ordinary people become "stranded" in the wild and are forced to live off the land. Yes, it's true, many of those shows are "staged," but what would you do if you were ever seriously lost or stranded and all you had to live off...
|
 | 5/15/2014 - Plastics, many of which are plastic bottles for juices, sodas, and water have created a huge planetary ecological disposal problem. Americans use an estimated 50 billion of these disposable plastic bottles annually. And they're made from around 1.5 million gallons of crude oil each year.
From a 2006...
|
 | 4/21/2014 - Imagine strolling through your town and finding the post office surrounded by raised beds, lush with produce that is free for the taking, 24/7. Or a police department with a gratis community vegetable garden, complete with curly kale, carrots, lettuces and onions. And orchards, as well as berry bushes,...
|
 | 2/11/2014 - Space is not the first place you think of when the subject turns to agriculture, but at some point in the future it might, thanks to some recent breakthroughs by Russian cosmonauts/scientists.
According to tech news site Betabeat and Russian media, "Russian space farmers" have managed to grow "a...
|
 | 11/13/2013 - The healing properties of mushrooms have been known for centuries. Traditional Chinese medicine, for instance, has long recommended the consumption of certain edible mushrooms to treat serious conditions such as diabetes and high blood pressure. Likewise, European civilizations have treasured the continent's...
|
 | 6/18/2013 - This is an urgent action alert from Natural News and the Health Ranger. Public comments are due by July 1 to object to new EPA regulations which are already in place, allowing glyphosate contamination of food crops, edible oils and waterways at concentrations which are thousands of times higher than...
|
 | 5/3/2013 - Instead of signing over your entire paycheck for organic produce, have you considered the bounty of nourishing fare growing wild right in your own backyard? Not surprisingly, edible weeds have come back into vogue as food prices continue to rise and budgets tighten. Tasty and nutritious, these humble...
|
 | 12/6/2012 - What used to be nothing more than barren, unused easement space for overhead utility lines in an ordinary southern California suburb has turned into a flourishing, edible landscape, thanks to the inspiration of several local visionaries who recognized incredible potential for the otherwise wasted site....
|
 | 9/19/2012 - Purple carrots, raspberry bushes and a bounty of schoolyard-grown vegetables are sprouting up around the nation. Edible schoolyards are teaching children about sustainability, nutrition and the fun of growing, cooking and eating their own food. As more of these gardens germinate from an idea to a full...
|
 | 8/2/2012 - What if a hurricane and disastrous man-made flood ruined the economy of your city to the point where children throughout the city could not get access to nourishing food?
Economic and nutritional degradation now sounds like most cities in America, even without a hurricane. The severe and epic disaster...
|
 | 6/26/2012 - Different local authorities throughout the USA have been harassing homeowners for growing veggies or herbs in their front lawns. But in the small town of Todmorden, England, a grass-roots food movement has been started by one woman who grew veggies in her front yard and let neighbors pick them free.
It...
|
 | 6/20/2012 - An Oklahoma woman is the latest victim of government terrorism after City of Tulsa code enforcement officials came to her house and illegally tore up her entire edible garden, which contained over 100 varieties of medicinal plants. Denise Morrison was in full compliance with local laws concerning her...
|
 | 1/20/2012 - Imagine a world where the government monitors everything you eat and drink, and makes sure you take all your pharmaceutical drugs by feeding you an edible microchip that transmits this compliance information remotely to authorities. Such a world is almost a reality, as a California-based biotechnology...
|
 | 1/19/2012 - Why should you care about wild edibles? Because many health experts agree that wild edibles are the highest quality, best foods available to eat. The NaturalNews Talk Hour presents "Wild Edibles - The Miracle of Greens" with our special guest Sergei Boutenko, raw food expert.
"I learn something new...
|
| 7/13/2011 - Over the past few years, many people have started drinking daily green smoothies and want to continue. But those same people are noticing that the greens can be the most expensive ingredient in the green smoothie. Plus, the prices of fresh produce are rising at tremendous speeds. Here are some ways...
|
 | 6/3/2011 - It will monitor your calorie intake, show from where your food was sourced, and even let you know when the food in your fridge is about to go bad -- these are some of the enticing claims made by the developers of a new system that embeds edible radio frequency identification (RFID) chips directly into...
|
| 2/4/2011 - During the gray of winter days, rejuvenate your health and palate with gorgeous edible flowers. The petals of these captivating plants host a variety of important nutrients while providing a burst of color and contrast to the diet. Growing edible flowers need not be saved for the spring; create a lovely...
|
| 3/25/2009 - A sure sign of spring is the return of green plants. Garlic mustard (Alliaria officinalis or Alliaria petiolata) is not only one of the first spring greens to appear, it is also edible and delicious. Garlic mustard is widespread: it grows along shaded roadsides, woody paths, and other shady areas. Garlic...
|
| 2/19/2009 - People have been eating flowers almost since the beginning of recorded time. Who knows what prompted the first floral snack? It could be that the flower looked so tasty somebody tried eating it. We can be glad, for flowers still provide a delightful addition to a healthy diet. Let's explore some of...
|
| 2/6/2009 - An edible film based on simple tomato puree might be able to protect foods from contamination by E. coli and other bacteria, according to a study conducted by researchers from the U.S. Department of Agriculture's Agriculture Research Service and the Western Regional Research Centre, Processed Foods,...
|
| 5/6/2008 - The Japanese started it with candy wrappers you could eat. Many readers may remember being fascinated by eating the wrappers containing Asian candy, even with Mom's permission! For almost ten years, vegetarians have happily consumed medications and food supplements in vegetarian capsules. Now, food...
|
Concept-related articles:Technology:Processed foods:Vitamins:Food safety:Minerals:Vegetables:Vitamin E:Science:Berries:Fruits:Consumers:Nature:Food:Health:Foods:Meat:
|
 |
Concepts related to Edible
View edible on NaturalPedia™
|
Today's Top Stories on NaturalNews
Today | Week | Month | Year
- Sugar takes on high fructose corn syrup in high stakes legal battle to see which is most unhealthy
- Cinnamon and honey's healing properties
- Peanut oil in vaccines behind widespread peanut allergy epidemic
- Four easy ways to improve your thyroid function
- Studies expose the ugly truth about antipsychotic drugs
- Tungsten in rice protein: Health Ranger releases new chart, petitions all protein manufacturers to commit to reasonable industry standards for heavy metals
- Natural News Labs publishes heavy metals test results for seaweeds and sea vegetables: Kelp, Kombu, Wakame, Nori, Dulse and more
- Kale is great for your sex life
- INVESTIGATION: Three days before Dr. Bradstreet was found dead in a river, U.S. govt. agents raided his research facility to seize a breakthrough cancer treatment called GcMAF
- Eight Remedies Treat Diabetes Naturally
- Your brain IS capable of producing new cells through neurogenesis; here are FIVE ways to improve cognition
- Gently detox with 4 superfoods to remove toxins from chem trails, heavy metals, noxious chemicals, pesticides, drugs, GMO by-products
- Frankenscientists announce mutant GMO cows to produce hormone-induced 'engineered' milk for human babies
- Use Hydrogen Peroxide to Heal and Stay Healthy
- The Six Healing Sounds: Sound Six, The Triple Burner
- Silymarin from milk thistle protects against liver damage and brain aging
- Homemade Essential Oil and Aromatherapy Fragrances Make Great Gifts
- Sungazing: Discover the bright rewards of this ancient practice
- The REAL FAKE NEWS exposed: '97% of scientists agree on climate change' is an engineered hoax... here's what the media never told you
- The best and worst forms of magnesium to take as a supplement
- Sugar takes on high fructose corn syrup in high stakes legal battle to see which is most unhealthy
- The remarkable health benefits of oil pulling
- Eliminate restless leg syndrome with home remedies and natural treatments
- Apricot Seeds Kill Cancer Cells without Side Effects
- Beat cancer with 35% hydrogen peroxide
- Water filters tested for heavy metals removal: Zero Water, Pur, Brita, Mavea, Culligan, Seychelle and Waterman
- Cinnamon and honey's healing properties
- Wisdom teeth surgery a deadly dental scam: Young mother falls into coma following visit to dentist
- The Bill of Rights is not negotiable - SHARE this urgent declaration
- Tungsten in rice protein: Health Ranger releases new chart, petitions all protein manufacturers to commit to reasonable industry standards for heavy metals
- INVESTIGATION: Three days before Dr. Bradstreet was found dead in a river, U.S. govt. agents raided his research facility to seize a breakthrough cancer treatment called GcMAF
- Top 9 natural ways to heal the physical and psychological causes of depression
- Full history exposed: Tribeca Film Festival carrying out Nazi agenda of genocide, eugenics and extermination via 'science' and medicine
- Dandelion root far more effective in fighting cancer cells than chemotherapy
- Medical journal openly questions science, ethics of HPV vaccinations
- Halt infectious disease, cancer and much more with $3 remedy
- The REAL FAKE NEWS exposed: '97% of scientists agree on climate change' is an engineered hoax... here's what the media never told you
- Bill Gates says vaccines can help reduce world population
- The best and worst forms of magnesium to take as a supplement
- NASA admits to spraying Americans with poisonous chemtrails
- Beat cancer with 35% hydrogen peroxide
- Peanut oil in vaccines behind widespread peanut allergy epidemic
- The best, and worst, laundry detergents with 1,4-dioxane contamination
- Feeding the soil: An introduction to the no-till gardening method
- Water filters tested for heavy metals removal: Zero Water, Pur, Brita, Mavea, Culligan, Seychelle and Waterman
- Apricot Seeds Kill Cancer Cells without Side Effects
- Eighteen Overlooked Symptoms of Adrenal Fatigue
- Study Reveals Serious HPV Vaccine Problems: Fainting, Blood Clots, Death Among Risks
- Forget Filling Cavities: Regrow Your Teeth Instead
- Six little-known natural remedies for tinnitus
- The MMR vaccine, autism connection
- 3 common parasites that are literally eating you alive
- HPV vaccines are harming and killing victims worldwide in a silent epidemic of medical violence against children
- Indian black salve: The magical cancer cure
See All Top Headlines...
Most Popular Stories
 |
TED aligns with Monsanto, halting any talks about GMOs, 'food as medicine' or natural healing |
|
 |
10 other companies that use the same Subway yoga mat chemical in their buns |
|
 |
Warning: Enrolling in Obamacare allows government to link your IP address with your name, social security number, bank accounts and web surfing habits |
|
 |
High-dose vitamin C injections shown to annihilate cancer |
|
 |
USDA to allow U.S. to be overrun with contaminated chicken from China |
|
 |
Vaccine fraud exposed: Measles and mumps making a huge comeback because vaccines are designed to fail, say Merck virologists |
|
 |
New USDA rule allows hidden feces, pus, bacteria and bleach in conventional poultry |
|
 |
Battle for humanity nearly lost: global food supply deliberately engineered to end life, not nourish it |
|
 |
Harvard research links fluoridated water to ADHD, mental disorders |
|
 |
10 outrageous (but true) facts about vaccines the CDC and the vaccine industry don't want you to know |
|
 |
EBT card food stamp recipients ransack Wal-Mart stores, stealing carts full of food during federal computer glitch |
|
 |
Cannabis kicks Lyme disease to the curb |
|
|
Recommended Resources
TV.NaturalNews.com is
a free video website featuring thousands of videos on holistic health, nutrition,
fitness, recipes, natural remedies and much more.
CounterThink Cartoons are
free to view and download. They cover topics like health, environment and freedom.
The Consumer Wellness Center is
a non-profit organization offering nutrition education grants to programs that
help children and expectant mothers around the world.
Food Investigations is
a series of mini-documentaries exposing the truth about dangerous ingredients
in the food supply.
Webseed.com offers
alternative health programs, documentaries and more.
The Honest Food Guide is
a free, downloadable public health and nutrition chart that dares to tell the
truth about what foods we should really be eating.
HealingFoodReference.com offers
a free online reference database of healing foods, phytonutrients and plant-based
medicines that prevent or treat diseases and health conditions.
HerbReference.com is
a free, online reference library that lists medicinal herbs and their health
benefits.
NutrientReference.com is
a free online reference database of phytonutrients (natural medicines found in
foods) and their health benefits. Lists diseases, foods, herbs and more.
|
|